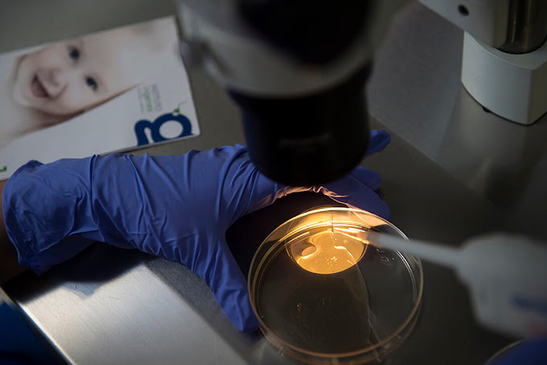
Slider image (8) Ingenes Monterrey

Request a video call
Confirm Your Virtual Consultation
Ingenes Monterrey Descripción general del perfil

Tabla de contenido • Procedimientos • Ventajas • Médicos • Cómo reservar |
Soluciones de vanguardia para la infertilidad en Ingenes en Monterrey, México
Ingenes Monterrey se dedica a brindar a los pacientes acceso a una amplia gama de tratamientos de reproducción asistida. Nuestro compromiso radica en ofrecer opciones avanzadas y mantener un equipo de profesionales con experiencia. Ubicados estratégicamente en el distrito comercial Nuevo Sur de Monterrey, nuestras instalaciones de 1,000 metros cuadrados garantizan un ambiente cálido y exclusivo para su viaje de fertilidad. Nuestros servicios integrales incluyen tratamientos de reproducción asistida, brindados por un equipo de más de 60 expertos multidisciplinarios en salud reproductiva.
Atención integral de FIV para los sueños de su familia
Ingenes Monterrey cuenta con instalaciones totalmente equipadas, que incluyen quirófano, área de recepción, sala de espera, consultorios médicos, laboratorios de FIV y andrología, y salas privadas de recuperación. Nuestro compromiso de cumplir los sueños familiares está respaldado por técnicas innovadoras como la Fertilización In Vitro (FIV) , ICSI , PICSI , Inseminación Artificial , Coito Programado , PGT-A , PGT-M , Implantation Score , Eligender , Clarix y acceso al Banco Internacional de Semen .
Técnicas innovadoras para la fertilidad de la pareja
Los avances en medicina reproductiva, incluidas técnicas como las pruebas genéticas preimplantacionales y la integración de inteligencia artificial, han transformado los tratamientos de fertilidad. Estas innovaciones no solo mejoran las tasas de concepción, sino que también brindan a las parejas información personalizada sobre su salud reproductiva, lo que les ofrece nuevas esperanzas en su camino hacia la fertilidad.
Especialistas líderes en FIV en Monterrey, México para parejas
Conozca al Dr. Enrique Rodríguez Villasana , Director Médico de Ingenes Monterrey. Con una especialización en Endocrinología Ginecológica e Infertilidad, el Dr. Villasana aporta una gran experiencia. Se graduó con honores de la Facultad de Medicina de Xalapa de la Universidad Autónoma Veracruzana, perfeccionó sus habilidades en el Centro Médico Nacional "La Raza" y obtuvo una maestría en Endocrinología Ginecológica e Infertilidad del Instituto de Fertilidad y Genética Ingenes, con el apoyo de la Universidad de Sonora.
Centro de FIV de confianza en Monterrey, México para la infertilidad
Ingenes Monterrey es un centro líder en FIV en Monterrey, México, que ofrece tecnologías reproductivas de vanguardia y atención compasiva. Especializado en tratamientos personalizados como FIV, IIU y preservación de la fertilidad, Ingenes Monterrey es un faro de esperanza para las personas que enfrentan la infertilidad, brindando soluciones personalizadas para ayudarlas a lograr su sueño de ser padres.
Excelencia en el cuidado de la fertilidad para parejas
En Ingenes Monterrey, la excelencia en el cuidado de la fertilidad no es solo un objetivo, sino un compromiso. Nuestro equipo de especialistas en tratamientos de fertilidad colabora a la perfección para brindar una atención integral, adoptando las últimas técnicas y tecnologías para garantizar los mejores resultados posibles para las parejas en su camino hacia la paternidad.
Tu camino personalizado hacia la paternidad comienza aquí
Ingenes Monterrey te invita a emprender un camino personalizado hacia la paternidad. Con instalaciones de última generación, un equipo de expertos dedicados y una gama de soluciones innovadoras de fertilidad, estamos aquí para guiarte y apoyarte en cada paso de tu viaje único hacia la creación de la familia de tus sueños. Haz clic en el botón de contacto a continuación para programar tu consulta hoy mismo.
Ubicación
Reviews

Acerca del Centro Médico
- Translations: EN ES
- Especialidad: Fertility Treatment, Infertility/IVF
- Ubicación: Ave. Revolucion 2703, Centro Empresarial Nuevo Sur Tower 1, fl 8, Col. Ladrillera, ZC. 64830, Monterrey, Nuevo Leon, Mexico. , Monterrey , Mexico
- Descripción general: Descubra la esperanza en Ingenes Monterrey. Los mejores tratamientos de fertilidad en Monterrey, México. Atención experta, tecnología avanzada. Su viaje hacia la paternidad comienza aquí.

.png)
.png)
.png)
.png)






Comparte este listado